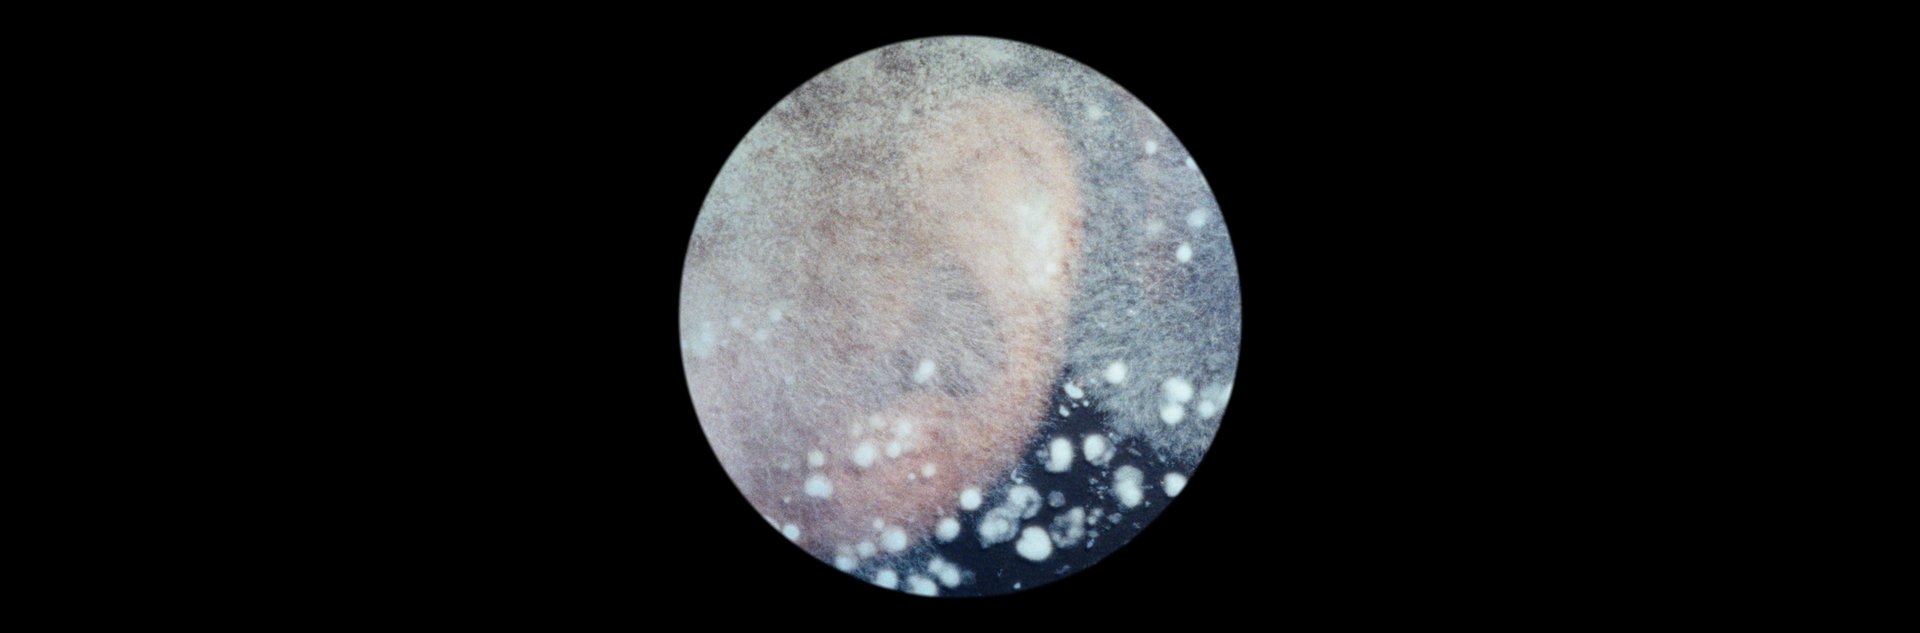

BIODESTRUKTORIAI
Lietuva, Prancūzija, Latvija 2025, 85 min., lietuvių k., ispanų k.
Režisierė: Aistė Žegulytė
Scenarijaus autorės: Aistė Žegulytė, Vėjūnė Tamuliūnaitė, Licia Eminenti
Operatorius: Vytautas Katkus LAC
Montuotojas: Danielius Kokanauskis
Prodiuseriai: Uljana Kim, Migla Butkutė (Studio Uljana Kim)
Kompozitorius: Gediminas Jakubka
Garso dizaineris: Ken Yasumoto
Biodestruktoriai – mikroskopiniai grybai, kurie gyveno milijonus metų iki žmogaus ir matyt gyvuos žmogui išnykus. Kol žmonės kovoja su laiku mėgindami išsaugoti meną, kūnus ir prisiminimus, čia įsiveržia – biodestruktoriai. Jie primena, jog visa kinta ir turi sunykti, kad atgimtų. Filmas kaip pro mikroskopo apskritimą žvelgia į žmonių ir grybų kultūras, ir skirtingą jų laiką.
Pagrindinė tema – transformacija, kurią metaforiškai įkūnija – mikrogrybai. Jie suvalgo daiktus, vėliau, patį žmogaus kūną. Bet viltis atsiranda pažvelgus per mikroskopą – tas stebuklų pasaulis naikina liūdesį, skausmą ir mirtį.





